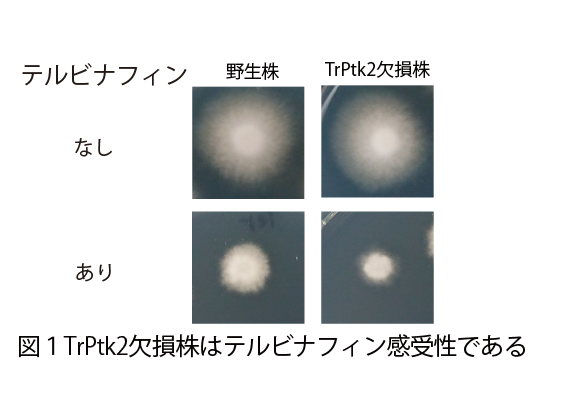
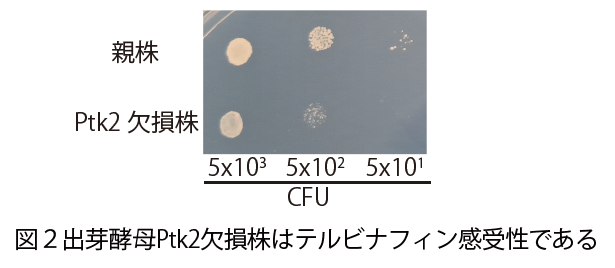
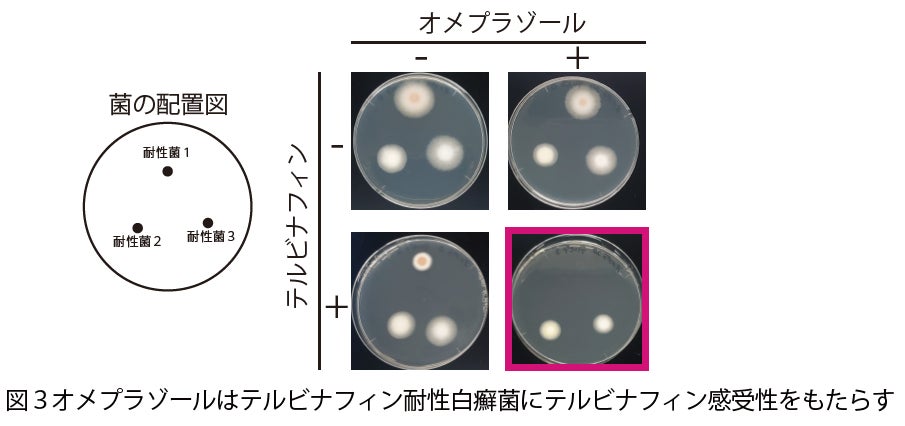
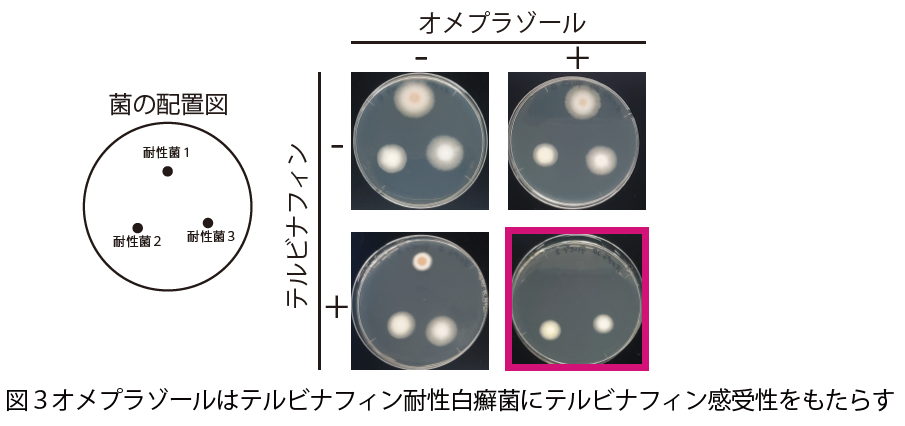

【武蔵野大学・帝京大学 共同プレスリリース】水虫治療薬に対する耐性真菌治療に向け新たな抗真菌療法を提案
本研究は、武蔵野大学 薬学部 薬学統合企画 共同研究ユニット『アンメットメディカルニーズを満たす新薬創生プロジェクト』と国内外の研究者とが協調することで得られた成果であり、近年報告の増加しているテルビナフィン耐性白癬菌に対する新たな治療薬の発見に繋がるものと期待されます。
本研究成果は、国際連合が定めた「持続可能な開発目標(SDGs)」のうち、「3.すべての人に健康と福祉を」に貢献するものです。
図:本研究のイメージ
【本研究成果のポイント】
水虫治療薬テルビナフィンに対する自然耐性に関与するタンパク質TrPtk2を同定
TrPtk2やプロトンポンプTrPma1が、テルビナフィンの抗真菌作用を増強する医薬品開発の作用標的候補となることを提唱
【本研究の背景】
白癬(はくせん)(水虫)は、国民病とも言われ、日本人の足白癬(あしはくせん)の罹患率は21.6%と推計されており*1、日本の人口が1億2000万人であることから、罹患者数は2500万人以上に上ると推測されます。水虫などの真菌(カビなど)による感染症治療薬はその種類が限られており、真菌の増殖に必要な細胞膜成分であるエルゴステロールの生成を阻害して、真菌の増殖を抑える抗真菌薬が主に用いられています。その中でも費用対効果が高く世界的に使用されているのがテルビナフィンです。近年、テルビナフィンに耐性を示す薬剤耐性真菌が発見され、日本国内でもテルビナフィン耐性白癬菌の報告が続いています。これからの耐性菌の更なる蔓延に対応するため、新たな治療法の開発が求められています。
【研究の内容と結果】
(1)白癬菌のテルビナフィン耐性に関与するタンパク質TrPtk2を同定
新たな抗真菌薬標的を探索するため、遺伝子組換え技術を用いて、白癬菌のもつ機能未知タンパク質TrPtk2を欠損させた変異株を作出したところ、野生株(遺伝子組換えをしていない元の菌株)と比べ、TrPtk2欠損株ではテルビナフィンを加えた培地*2における菌の成長が抑制される状態(感受性)になることが分かりました(図1)。 白癬菌以外の真菌も感染症を引き起こし、臨床上問題となります。そこで、白癬菌だけでなく他の真菌種においてもPtk2がテルビナフィンの自然耐性に関与するかを知るために、一般的に実験室で用いられている真菌の一種である出芽酵母を用いて調査しました。
その結果、出芽酵母においてPtk2タンパク質を欠損するとテルビナフィンの抗菌活性が上昇することを見出しました(図2)。これらのことから、Ptk2タンパク質が種を超えてテルビナフィンに対する自然耐性を付与することが示唆され、Ptk2が感染症を引き起こす様々な真菌に対する抗真菌薬を探索するうえで有力な標的候補であるとわかりました。
(2)プロトンポンプ*3阻害剤オメプラゾールは、テルビナフィン耐性白癬菌に対し、テルビナフィンの抗菌活性を上昇させることを発見
Ptk2は、細胞膜上のプロトンポンプPma1を活性化することが知られています。白癬菌のTrPtk2もプロトンポンプPma1を活性化し、テルビナフィン耐性をもたらすのではないかと考え、プロトンポンプ阻害剤として知られる胃酸抑制薬オメプラゾールを作用させた際のテルビナフィン感受性を確認しました。その結果、テルビナフィン耐性白癬菌においてテルビナフィンに部分的な感受性を示すことがわかりました(図3)。
以上の結果から、白癬菌TrPtk2-TrPma1経路が、近年報告が増加しているテルビナフィン耐性白癬菌に対する新たな治療標的となり、新規医薬品の発見につながるものと期待されます。
【出典・用語解説】
*1 日本皮膚科学会皮膚真菌症診療ガイドライン 2019
*2 培地:細胞や微生物が成長しやすいよう人工的に作られた環境のこと。
*3 プロトンポンプ:細胞内のエネルギーを利用して、H+(プロトン)を細胞の外に汲み出すタンパク質。胃が酸性なのは、このプロトンポンプが働くためであり、病原性真菌にとっても生きるために必要なタンパク質である。
【研究支援】
本研究成果は、以下の助成を受けて行われました。
・日本学術振興会 科学研究費助成事業 若手研究(21K15438、代表:石井 雅樹)
・日本学術振興会 科学研究費助成事業科研費 基盤研究(C) (23K06533、代表:石井 雅樹)
・武田科学振興財団 薬学系研究助成(代表:大畑 慎也)
・武蔵野大学 大学研究費(代表:大畑 慎也)
【論文タイトルと著者】

タイトル | The Ptk2-Pma1 pathway enhances tolerance to terbinafine in Trichophyton rubrum |
著者 | Masaki Ishii, Tsuyoshi Yamada, Kazuki Ishikawa, Koji Ichinose, Michel Monod, Shinya Ohata. |
掲載紙 | Antimicrobial Agents and Chemotherapy DOI: https://doi.org/10.1128/aac.01609-23 |
【関連リンク】
■武蔵野大学薬学部薬学科:https://www.musashino-u.ac.jp/academics/faculty/pharmacy
■帝京大学医真菌研究センター:https://www.teikyo-u.ac.jp/affiliate/laboratory/timm
■Antimicrobial Agents and Chemotherapy(本研究成果掲載紙):https://journals.asm.org/doi/10.1128/aac.01609-23
【問合せ先】
■武蔵野大学
薬学部薬学科 准教授 大畑 慎也、講師 石井 雅樹
TEL:042-468-8664
E-mail:m_ishii@musashino-u.ac.jp
経営企画部広報課(担当:谷内田)
TEL:03-5530-7403
E-mail:kouhou@musashino-u.ac.jp
■帝京大学 本部広報課(担当:守川)
TEL:03-3964-4162
E-mail:kouhou@teikyo-u.ac.jp
このプレスリリースには、メディア関係者向けの情報があります
メディアユーザー登録を行うと、企業担当者の連絡先や、イベント・記者会見の情報など様々な特記情報を閲覧できます。※内容はプレスリリースにより異なります。
すべての画像
